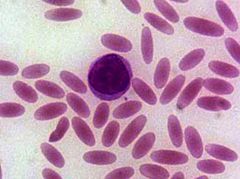

خلايا السيجار
خلايا السيجار (Cigar cells)
| Blood smear showing elliptocytes | |
| ICD-10 | D58.1 |
| ICD-9 | 282.1 |
| DiseasesDB | 4172 |
| eMedicine | ped/987 med/648 |
| MeSH | D004612 |
خلايا السيجار هي خلايا دم حمراء تكون على شكل سيجارة أو قلم رصاص على مسحة الدم المحيطي .تترافق عادةً خلايا السيجار مع كثرة الكريات الإهليلجية الوراثية . لذلك قد ترى أيضاً في فقر الدم بسبب نقص الحديد و الحالات المرضية الأخرى التي تنقص تقلب و أو إنتاج خلايا الدم الحمراء .[1] في حالة فقر الدم بسبب نقص الحديد فإنه يتوقع أيضاً أن يكون هناك صغر في الكريات الحمراء و نقص الانصباغ .

Blood films, Giemsa stained
المراجع
- ^ Clinical Hematology and Oncology. Bruce Furie, Peter A. Cassileth, Michael B. Atkins, Robert J. Mayer. Churchill Livingstone Publishing, ISBN 0-443-06556-X, pg. 276-78
This article may include material from Wikimedia licensed under CC BY-SA 4.0. Please comply with the license terms.